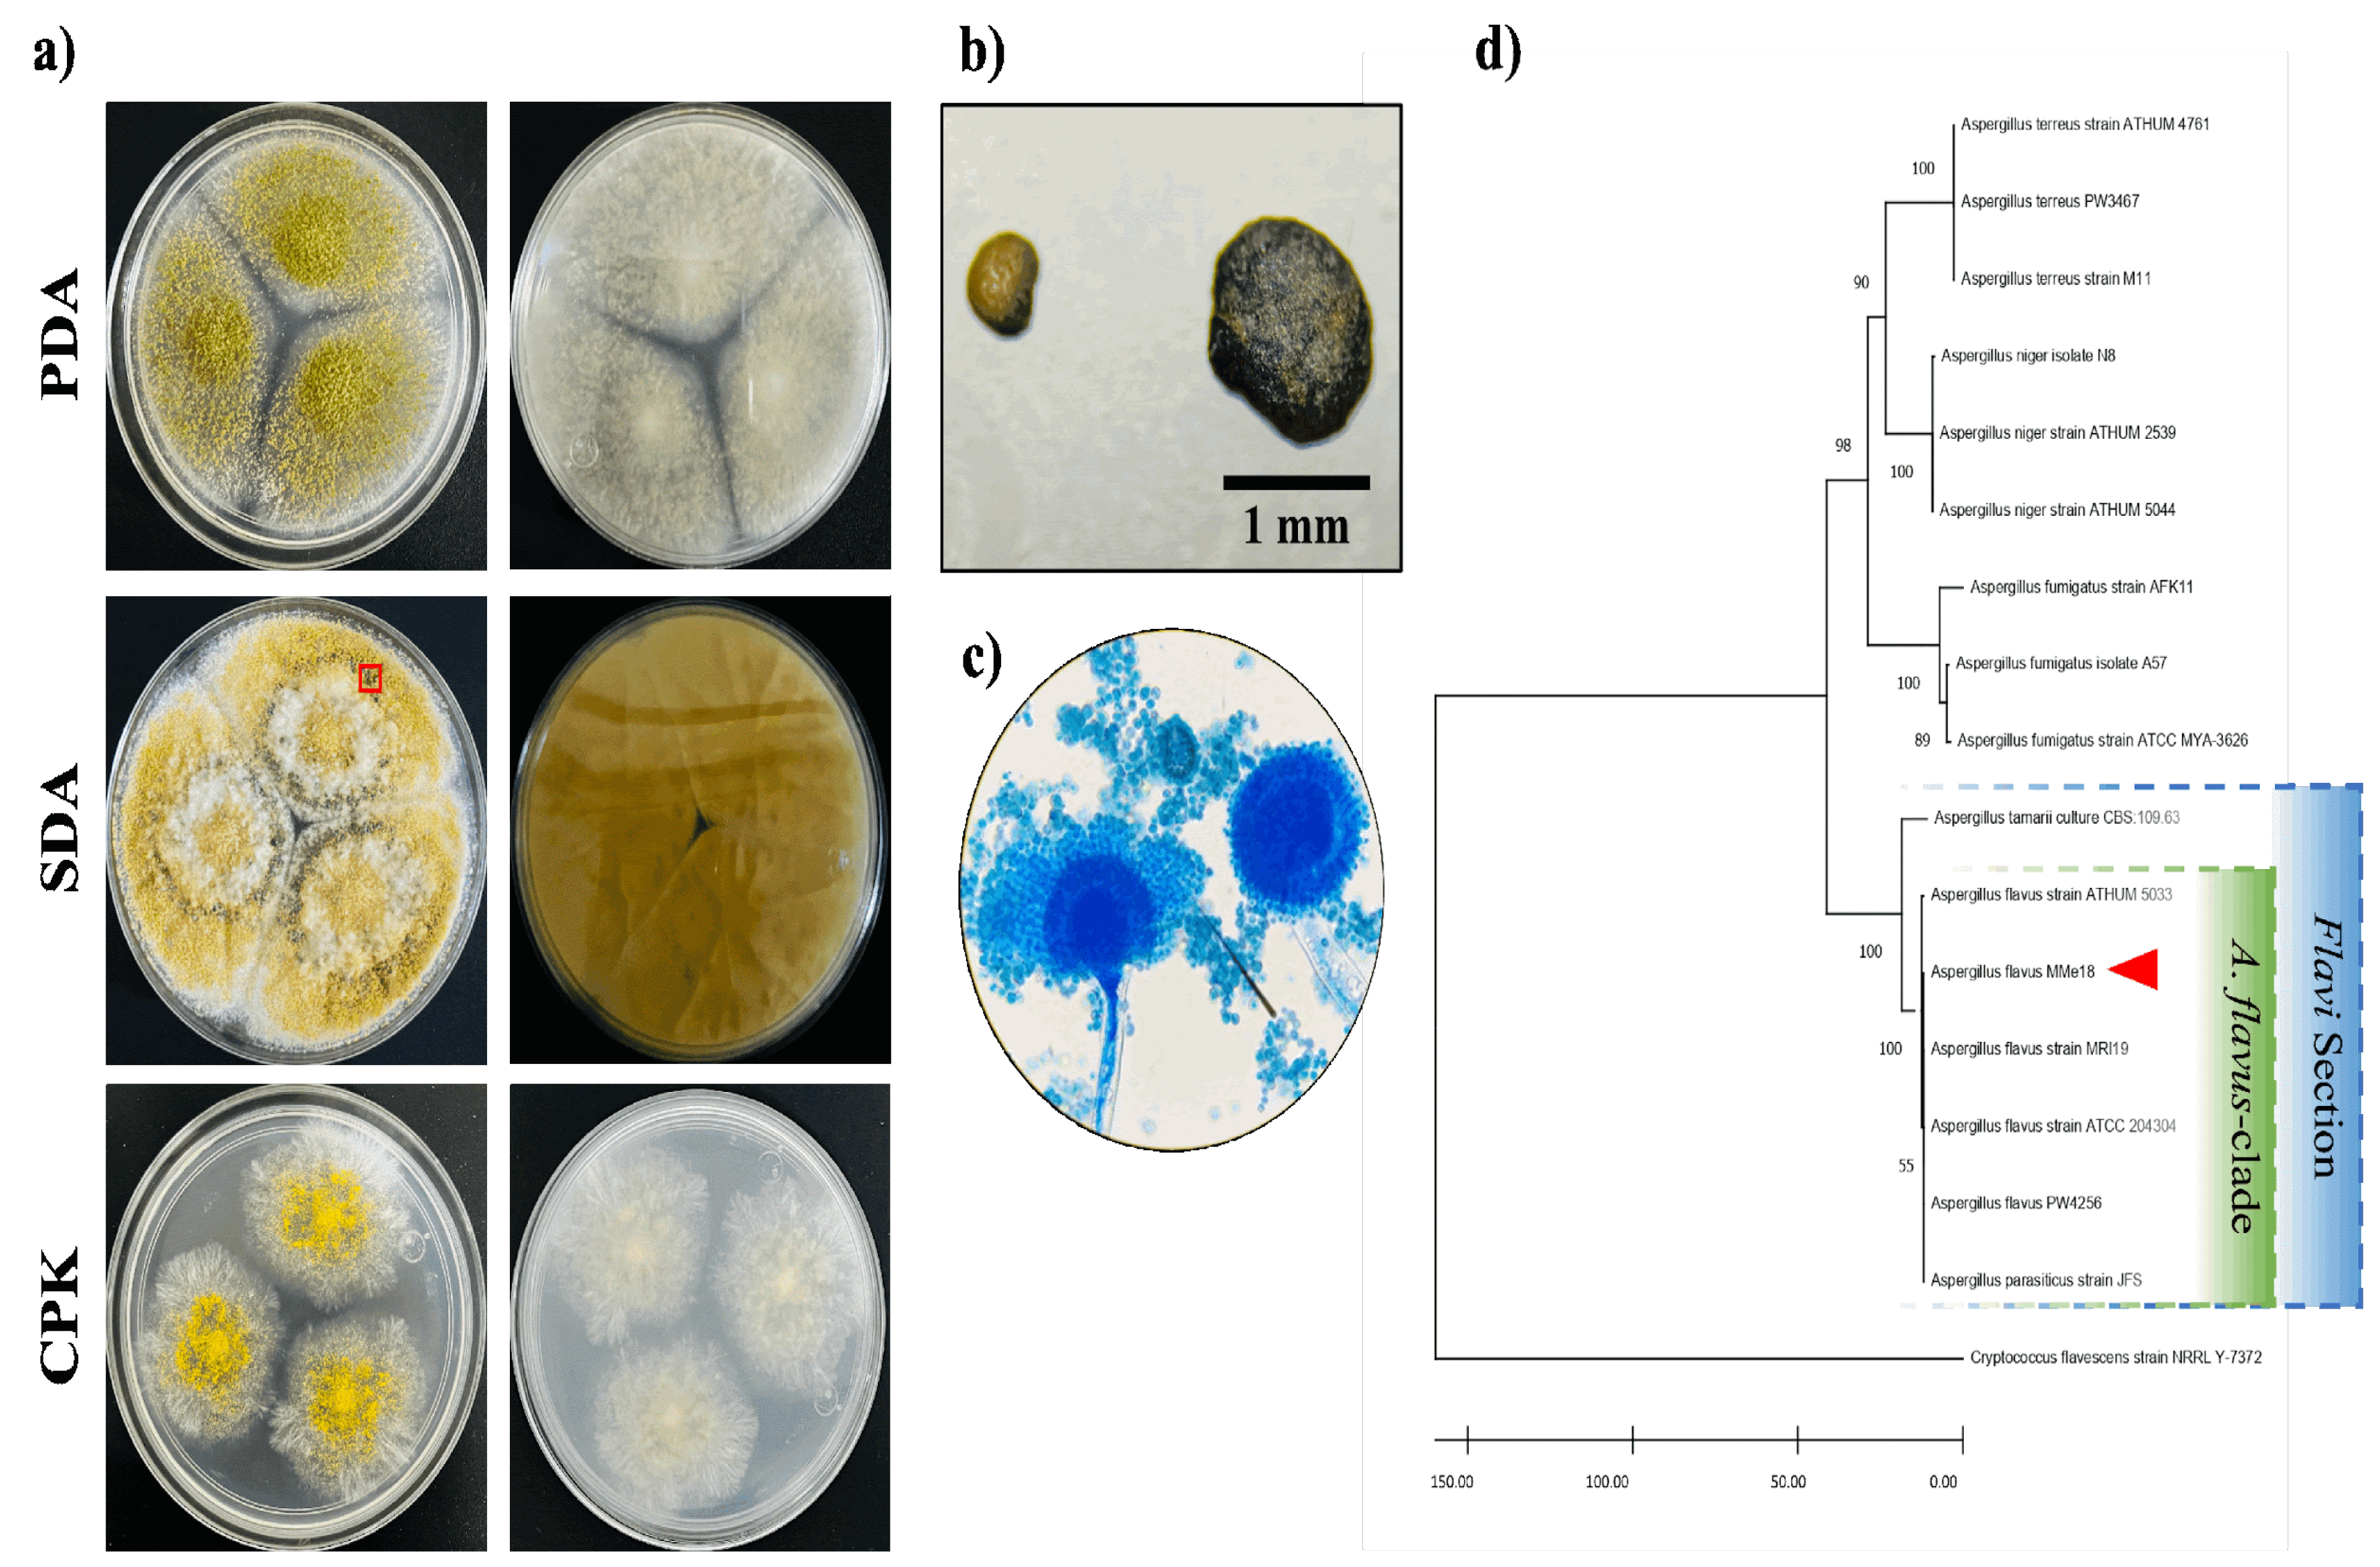
Preprints 118086 g001

Submitted:
12 September 2024
Posted:
13 September 2024
You are already at the latest version
Abstract
Keywords:
1. Introduction
2. Materials and Methods
2.1. Biological Material and Identification
2.2. Aspergillus flavus MMe18 Growth at Different Temperatures
2.3. Germination of Aspergillus flavus MMe18 Conidia
2.4. Aspergillus flavus MMe18 In Vitro Biofilm Formation
2.5. Biofilm aRchitecture of Aspergillus flavus MMe18
2.6. Biochemical Composition of the Extracellular Matrix
2.7. Antifungal Susceptibility Profile of A. flavus MMe18 at Different Temperatures
3. Results
3.1. Morphological and Molecular Identification
3.2. Optimal Growth Conditions for Aspergillus flavus
3.3. Temperature Accelerates Conidial Germination of Aspergillus flavus
3.4. Aspergillus Flavus In Vitro Biofilm is Favored by Temperature
3.5. Architecture of the Aspergillus flavus Biofilm
3.6. Biochemical Composition of the Aspergillus flavus Mature Biofilm
3.7. Antifungal Susceptibility Profile of A. flavus MMe18 as Planktonic Cells or as Biofilm
4. Discussion
5. Conclusions
Supplementary Materials
Author Contributions
Funding
Institutional Review Board Statement
Informed Consent Statement
Data Availability Statement
Acknowledgments
Conflicts of Interest
References
- Viegas, C.; Gomes, B.; Dias, M.; Carolino, E.; Aranha Caetano, L. Aspergillus Section Fumigati in Firefighter Headquarters. Microorganisms 2021, 9(10), 2112. [Google Scholar] [CrossRef] [PubMed]
- Sugui, J.A.; Kwon-Chung, K.J.; Juvvadi, P.R.; Latge, J.-P.; Steinbach, W.J. Aspergillus fumigatus and Related Species. Cold Spring Harb. Perspect. Med. 2015, 5(2), a019786. [Google Scholar] [CrossRef] [PubMed]
- Krishnan, S.; Manavathu, E.K.; Chandrasekar, P.H. Aspergillus flavus: An Emerging Non-fumigatus Aspergillus Species of Significance. Mycoses 2009, 52(3), 206–222. [Google Scholar] [CrossRef] [PubMed]
- Rudramurthy, S.M.; Paul, R.A.; Chakrabarti, A.; Mouton, J.W.; Meis, J.F. Invasive Aspergillosis by Aspergillus flavus: Epidemiology, Diagnosis, Antifungal Resistance, and Management. JoF 2019, 5(3), 55. [Google Scholar] [CrossRef]
- Al-Hatmi, A.M.S.; Castro, M.A.; De Hoog, G.S.; Badali, H.; Alvarado, V.F.; Verweij, P.E.; Meis, J.F.; Zago, V.V. Epidemiology of Aspergillus Species Causing Keratitis in Mexico. Mycoses 2019, 62(2), 144–151. [Google Scholar] [CrossRef]
- Badiee, P.; Alborzi, A.; Nejabat, M. Detection of Aspergillus Keratitis in Ocular Infections by Culture and Molecular Method. Int. Ophthalmol. 2011, 31(4), 291–296. [Google Scholar] [CrossRef]
- Lee, C.-Y.; Ho, Y.-J.; Sun, C.-C.; Lin, H.-C.; Hsiao, C.-H.; Ma, D.H.-K.; Lai, C.-C.; Chen, H.-C. Recurrent Fungal Keratitis and Blepharitis Caused by Aspergillus flavus. The American Society of Tropical Medicine and Hygiene 2016, 95(5), 1216–1218. [Google Scholar] [CrossRef]
- Pasqualotto, A.C.; Denning, D.W. An Aspergilloma Caused by Aspergillus flavus. Med. Mycol. 2008, 46(3), 275–278. [Google Scholar] [CrossRef]
- Martinez-Pajares, J.D.; Martinez-Ferriz, M.C.; Moreno-Perez, D.; Garcia-Ramirez, M.; Martin-Carballido, S.; Blanch-Iribarne, P. Management of Obstructive Renal Failure Caused by Bilateral Renal Aspergilloma in an Immunocompetent Newborn. J. Med. Microbiol. 2010, 59(3), 367–369. [Google Scholar] [CrossRef]
- Singal, A.; Grover, C.; Pandhi, D.; Das, S.; Jain, B. Nosocomial Urinary Tract Aspergilloma in an Immunocompetent Host: An Unusual Occurrence. Indian. J. Dermatol. 2013, 58(5), 408. [Google Scholar] [CrossRef]
- Gheisari, M.; Basharzad, N.; Yazdani Charati, J.; Mirenayat, M.S.; Pourabdollah, M.; Ansari, S.; Mortezaee, V.; Abastabar, M.; Jafarzadeh, J.; Haghani, I.; Hedayati, M.T. Galactomannan Detection in Bronchoalveolar Lavage Fluids: A Diagnostic Approach for Fungus Ball in Patients with Pulmonary Tuberculosis? Mycoses 2020, 63(7), 755–761. [Google Scholar] [CrossRef] [PubMed]
- Bernardeschi, C.; Foulet, F.; Ingen-Housz-Oro, S.; Ortonne, N.; Sitbon, K.; Quereux, G.; Lortholary, O.; Chosidow, O.; Bretagne, S. Cutaneous Invasive Aspergillosis: Retrospective Multicenter Study of the French Invasive-Aspergillosis Registry and Literature Review. Medicine 2015, 94(26), e1018. [Google Scholar] [CrossRef] [PubMed]
- Singh, S.A.; Dutta, S.; Narang, A.; Vaiphei, K. Cutaneous Aspergillus flavus Infection in a Neonate. Indian. J. Pediatr. 2004, 71(4), 351–352. [Google Scholar] [CrossRef] [PubMed]
- Merad, Y.; Derrar, H.; Belmokhtar, Z.; Belkacemi, M. Aspergillus Genus and Its Various Human Superficial and Cutaneous Features. Pathogens 2021, 10(6), 643. [Google Scholar] [CrossRef] [PubMed]
- Bhatnagar-Mathur, P.; Sunkara, S.; Bhatnagar-Panwar, M.; Waliyar, F.; Sharma, K.K. Biotechnological Advances for Combating Aspergillus flavus and Aflatoxin Contamination in Crops. Plant Sci. 2015, 234, 119–132. [Google Scholar] [CrossRef]
- Alshannaq, A.F.; Gibbons, J.G.; Lee, M.-K.; Han, K.-H.; Hong, S.-B.; Yu, J.-H. Controlling Aflatoxin Contamination and Propagation of Aspergillus flavus by a Soy-Fermenting Aspergillus oryzae Strain. Sci. Rep. 2018, 8(1), 16871. [Google Scholar] [CrossRef]
- Mamo, F.T.; Shang, B.; Selvaraj, J.N.; Wang, Y.; Liu, Y. Isolation and Characterization of Aspergillus flavus Strains in China. J. Microbiol. 2018, 56(2), 119–127. [Google Scholar] [CrossRef]
- Wang, P.; Chang, P.-K.; Kong, Q.; Shan, S.; Wei, Q. Comparison of Aflatoxin Production of Aspergillus flavus at Different Temperatures and Media: Proteome Analysis Based on TMT. Int. J. Food Microbiol. 2019, 310, 108313. [Google Scholar] [CrossRef]
- Kwon-Chung, K.J.; Sugui, J.A. Aspergillus fumigatus—What Makes the Species a Ubiquitous Human Fungal Pathogen? PLoS Pathog. 2013, 9(12), e1003743. [Google Scholar] [CrossRef]
- Araujo, R.; Rodrigues, A.G. Variability of Germinative Potential among Pathogenic Species of Aspergillus. J. Clin. Microbiol. 2004, 42(9), 4335–4337. [Google Scholar] [CrossRef]
- Bhabhra, R.; Askew, D.S. Thermotolerance and Virulence of Aspergillus fumigatus: Role of the Fungal Nucleolus. Med. Mycol. 2005, 43 (s1), 87–93. [Google Scholar] [CrossRef]
- Seyedmousavi, S.; Guillot, J.; Arné, P.; De Hoog, G.S.; Mouton, J.W.; Melchers, W.J.G.; Verweij, P.E. Aspergillus and Aspergilloses in Wild and Domestic Animals: A Global Health Concern with Parallels to Human Disease. Med. Myco. 2015, 53(8), 765–797. [Google Scholar] [CrossRef] [PubMed]
- Hedayati, M.T.; Pasqualotto, A.C.; Warn, P.A.; Bowyer, P.; Denning, D.W. Aspergillus flavus: Human Pathogen, Allergen and Mycotoxin Producer. Microbiology 2007, 153(6), 1677–1692. [Google Scholar] [CrossRef] [PubMed]
- Shabeer, S.; Asad, S.; Jamal, A.; Ali, A. Aflatoxin Contamination, Its Impact and Management Strategies: An Updated Review. Toxins 2022, 14(5), 307. [Google Scholar] [CrossRef] [PubMed]
- Hagiwara, D.; Sakamoto, K.; Abe, K.; Gomi, K. Signaling Pathways for Stress Responses and Adaptation in Aspergillus Species: Stress Biology in the Post-Genomic Era. Biosci. Biotechnol. Biochem. 2016, 80(9), 1667–1680. [Google Scholar] [CrossRef]
- Horianopoulos, L.C.; Kronstad, J.W. Chaperone Networks in Fungal Pathogens of Humans. JoF 2021, 7(3), 209. [Google Scholar] [CrossRef]
- Hagiwara, D.; Sakai, K.; Suzuki, S.; Umemura, M.; Nogawa, T.; Kato, N.; Osada, H.; Watanabe, A.; Kawamoto, S.; Gonoi, T.; Kamei, K. Temperature during Conidiation Affects Stress Tolerance, Pigmentation, and Trypacidin Accumulation in the Conidia of the Airborne Pathogen Aspergillus fumigatus. PLoS ONE 2017, 12(5), e0177050. [Google Scholar] [CrossRef]
- Fabri, J.H.T.M.; Rocha, M.C.; Fernandes, C.M.; Persinoti, G.F.; Ries, L.N.A.; Cunha, A.F.D.; Goldman, G.H.; Del Poeta, M.; Malavazi, I. The Heat Shock Transcription Factor HsfA Is Essential for Thermotolerance and Regulates Cell Wall Integrity in Aspergillus fumigatus. Front. Microbiol. 2021, 12, 656548. [Google Scholar] [CrossRef]
- Ramage, G.; Rajendran, R.; Gutierrez-Correa, M.; Jones, B.; Williams, C. Aspergillus Biofilms: Clinical and Industrial Significance. FEMS Microbiol. Lett. 2011, 324(2), 89–97. [Google Scholar] [CrossRef]
- Nett, J.; Lincoln, L.; Marchillo, K.; Massey, R.; Holoyda, K.; Hoff, B.; VanHandel, M.; Andes, D. Putative Role of β-1,3 Glucans in Candida albicans Biofilm Resistance. Antimicrob. Agents Chemother. 2007, 51(2), 510–520. [Google Scholar] [CrossRef]
- Pereira, R.; Santos Fontenelle, R.O.; Brito, E.H.S.; Morais, S.M. Biofilm of Candida albicans: Formation, Regulation and Resistance. J. Appl. Microbiol. 2021, 131(1), 11–22. [Google Scholar] [CrossRef] [PubMed]
- Kowalski, C.H.; Morelli, K.A.; Schultz, D.; Nadell, C.D.; Cramer, R.A. Fungal Biofilm Architecture Produces Hypoxic Microenvironments That Drive Antifungal Resistance. Proc. Natl. Acad. Sci. U.S.A. 2020, 117(36), 22473–22483. [Google Scholar] [CrossRef] [PubMed]
- Seidler, M.J.; Salvenmoser, S.; Müller, F.-M.C. Aspergillus fumigatus Forms Biofilms with Reduced Antifungal Drug Susceptibility on Bronchial Epithelial Cells. Antimicrob. Agents Chemother. 2008, 52(11), 4130–4136. [Google Scholar] [CrossRef] [PubMed]
- Garcia-Solache, M.A.; Casadevall, A. Global Warming Will Bring New Fungal Diseases for Mammals. mBio 2010, 1(1), e00061-10. [Google Scholar] [CrossRef] [PubMed]
- Parsons, M.G.; Diekema, D.J. What Is New in Fungal Infections? Modern Pathology 2023, 36(6), 100187. [Google Scholar] [CrossRef]
- Seidel, D.; Wurster, S.; Jenks, J.D.; Sati, H.; Gangneux, J.-P.; Egger, M.; Alastruey-Izquierdo, A.; Ford, N.P.; Chowdhary, A.; Sprute, R.; Cornely, O.; Thompson, G.R.; Hoenigl, M.; Kontoyiannis, D.P. Impact of Climate Change and Natural Disasters on Fungal Infections. The Lancet Microbe 2024, 5(6), e594–e605. [Google Scholar] [CrossRef]
- Rodríguez-Tovar, A.V.; Ruiz-Medrano, R.; Herrera-Martínez, A.; Barrera-Figueroa, B.E.; Hidalgo-Lara, M.E.; Reyes-Márquez, B.E.; Cabrera-Ponce, J.L.; Valdés, M.; Xoconostle-Cázares, B. Stable Genetic Transformation of the Ectomycorrhizal Fungus Pisolithus tinctorius. J. Microbiol. Methods 2005, 63(1), 45–54. [Google Scholar] [CrossRef]
- Perera, M.; Wijayarathna, D.; Wijesundera, S.; Chinthaka, M.; Seneviratne, G.; Jayasena, S. Biofilm Mediated Synergistic Degradation of Hexadecane by a Naturally Formed Community Comprising Aspergillus flavus Complex and Bacillus cereus Group. BMC Microbiol. 2019, 19(1), 84. [Google Scholar] [CrossRef]
- Hedayati, M.T.; Taghizadeh-Armaki, M.; Zarrinfar, H.; Hoseinnejad, A.; Ansari, S.; Abastabar, M.; Er, H.; Özhak, B.; Öğünç, D.; Ilkit, M.; Seyedmousavi, S. Discrimination of Aspergillus flavus from Aspergillus oryzae by Matrix-assisted Laser Desorption/Ionisation Time-of-flight (MALDI-TOF) Mass Spectrometry. Mycoses 2019, 62(12), 1182–1188. [Google Scholar] [CrossRef]
- Córdova-Alcántara, I.M.; Venegas-Cortés, D.L.; Martínez-Rivera, M.Á.; Pérez, N.O.; Rodriguez-Tovar, A.V. Biofilm Characterization of Fusarium solani Keratitis Isolate: Increased Resistance to Antifungals and UV Light. J. Microbiol. 2019, 57(6), 485–497. [Google Scholar] [CrossRef]
- Christensen, G.D.; Simpson, W.A.; Younger, J.J.; Baddour, L.M.; Barrett, F.F.; Melton, D.M.; Beachey, E.H. Adherence of Coagulase-Negative Staphylococci to Plastic Tissue Culture Plates: A Quantitative Model for the Adherence of Staphylococci to Medical Devices. J. Clin. Microbiol. 1985, 22(6), 996–1006. [Google Scholar] [CrossRef] [PubMed]
- Peeters, E.; Nelis, H.J.; Coenye, T. Comparison of Multiple Methods for Quantification of Microbial Biofilms Grown in Microtiter Plates. J. Microbiol. Methods 2008, 72(2), 157–165. [Google Scholar] [CrossRef]
- Ramírez Granillo, A.; Canales, M.G.M.; Espíndola, M.E.S.; Martínez Rivera, M.A.; De Lucio, V.M.B.; Tovar, A.V.R. Antibiosis Interaction of Staphylococccus aureus on Aspergillus fumigatus Assessed in vitro by Mixed Biofilm Formation. BMC Microbiol. 2015, 15(1), 33. [Google Scholar] [CrossRef] [PubMed]
- M38-A Reference Method for Broth Dilution Antifungal Susceptibility Testing of Filamentous Fungi; Approved Standard.
- Fortún, J.; Meije, Y.; Fresco, G.; Moreno, S. Aspergilosis. Formas clínicas y tratamiento. Enferm. Infecc. Microbiol. Clin. 2012, 30(4), 201–208. [Google Scholar] [CrossRef]
- Pasqualotto, A.C. Differences in Pathogenicity and Clinical Syndromes Due to Aspergillus fumigatus and Aspergillus flavus. Med. Mycol. 2009, 47(s1), S261–S270. [Google Scholar] [CrossRef]
- Horn, B.W.; Sorensen, R.B.; Lamb, M.C.; Sobolev, V.S.; Olarte, R.A.; Worthington, C.J.; Carbone, I. Sexual Reproduction in Aspergillus flavus Sclerotia Naturally Produced in Corn. Phytopathology 2014, 104(1), 75–85. [Google Scholar] [CrossRef] [PubMed]
- Ohkura, M.; Cotty, P.J.; Orbach, M.J. Comparative Genomics of Aspergillus flavus S and L Morphotypes Yield Insights into Niche Adaptation. G3 Genes|Genomes|Genetics 2018, 8(12), 3915–3930. [Google Scholar] [CrossRef] [PubMed]
- Frisvad, J.C.; Hubka, V.; Ezekiel, C.N.; Hong, S.-B.; Nováková, A.; Chen, A.J.; Arzanlou, M.; Larsen, T.O.; Sklenář, F.; Mahakarnchanakul, W.; Samson, R.A.; Houbraken, J. Taxonomy of Aspergillus Section Flavi and Their Production of Aflatoxins, Ochratoxins and Other Mycotoxins. Stud. Mycol. 2019, 93(1), 1–63. [Google Scholar] [CrossRef]
- Evans, S.S.; Repasky, E.A.; Fisher, D.T. Fever and the Thermal Regulation of Immunity: The Immune System Feels the Heat. Nat. Rev. Immunol. 2015, 15(6), 335–349. [Google Scholar] [CrossRef]
- Kousha, M.; Tadi, R.; Soubani, A.O. Pulmonary Aspergillosis: A Clinical Review. Eur. Respir. Rev. 2011, 20(121), 156–174. [Google Scholar] [CrossRef]
- Sunnetcioglu, A.; Ekin, S.; Erten, R.; Parlak, M.; Esen, R. Endobronchial Aspergilloma: A Case Report. Respir. Med. Case Rep. 2016, 18, 1–3. [Google Scholar] [CrossRef]
- Boral, H.; Metin, B.; Döğen, A.; Seyedmousavi, S.; Ilkit, M. Overview of Selected Virulence Attributes in Aspergillus fumigatus, Candida albicans, Cryptococcus neoformans, Trichophyton rubrum, and Exophiala dermatitidis. Fungal Genet. Biol. 2018, 111, 92–107. [Google Scholar] [CrossRef] [PubMed]
- Ford, S.; Friedman, L. Experimental Study of the Pathogenicity of Aspergilli for Mice. J. Bacteriol. 1967, 94(4), 928–933. [Google Scholar] [CrossRef] [PubMed]
- Usman, S.; Du, C.; Qin, Q.; Odiba, A.S.; He, R.; Wang, B.; Jin, C.; Fang, W. Phosphomannose Isomerase Is Involved in Development, Stress Responses, and Pathogenicity of Aspergillus flavus. Microbiol. Spectr. 2022, 10(5), e02027-22. [Google Scholar] [CrossRef] [PubMed]
- Chakrabarti, A.; Jatana, M.; Sharma, S.C. Rabbit as an Animal Model of Paranasal Sinus Mycoses. Med. Mycol. 1997, 35(4), 295–297. [Google Scholar] [CrossRef] [PubMed]
- Dagenais, T.R.T.; Keller, N.P. Pathogenesis of Aspergillus Fumigatus in Invasive Aspergillosis. Clin. Microbiol. Rev. 2009, 22(3), 447–465. [Google Scholar] [CrossRef]
- Morelli, K.A.; Kerkaert, J.D.; Cramer, R.A. Aspergillus Fumigatus Biofilms: Toward Understanding How Growth as a Multicellular Network Increases Antifungal Resistance and Disease Progression. PLoS Pathog. 2021, 17(8), e1009794. [Google Scholar] [CrossRef]
- González-Ramírez, A.I.; Ramírez-Granillo, A.; Medina-Canales, M.G.; Rodríguez-Tovar, A.V.; Martínez-Rivera, M.A. Analysis and Description of the Stages of Aspergillus fumigatus Biofilm Formation Using Scanning Electron Microscopy. BMC Microbiol. 2016, 16(1), 243. [Google Scholar] [CrossRef]
- Kumar, V.; Singh, G.P.; Babu, A.M. Surface Ultrastructural Studies on the Germination, Penetration and Conidial Development of Aspergillus flavus Link: Fries Infecting Silkworm, Bombyx Mori Linn. Mycopathologia 2004, 157(1), 127–135. [Google Scholar] [CrossRef]
- Úrbez-Torres, J.R.; Bruez, E.; Hurtado, J.; Gubler, W.D. Effect of Temperature on Conidial Germination of Botryosphaeriaceae Species Infecting Grapevines. Plant Dis. 2010, 94(12), 1476–1484. [Google Scholar] [CrossRef]
- Baltussen, T.J.H.; Zoll, J.; Verweij, P.E.; Melchers, W.J.G. Molecular Mechanisms of Conidial Germination in Aspergillus spp. Microbiol. Mol. Biol. Rev. 2020, 84(1), e00049-19. [Google Scholar] [CrossRef]
- Ciofu, O.; Moser, C.; Jensen, P.Ø.; Høiby, N. Tolerance and Resistance of Microbial Biofilms. Nat. Rev. Microbiol. 2022, 20(10), 621–635. [Google Scholar] [CrossRef] [PubMed]
- Costa-Orlandi, C.; Sardi, J.; Pitangui, N.; De Oliveira, H.; Scorzoni, L.; Galeane, M.; Medina-Alarcón, K.; Melo, W.; Marcelino, M.; Braz, J.; Fusco-Almeida, A.; Mendes-Giannini, M. Fungal Biofilms and Polymicrobial Diseases. JoF 2017, 3(2), 22. [Google Scholar] [CrossRef] [PubMed]
- Mowat, E.; Butcher, J.; Lang, S.; Williams, C.; Ramage, G. Development of a Simple Model for Studying the Effects of Antifungal Agents on Multicellular Communities of Aspergillus fumigatus. Journal Med. Microbiol. 2007, 56(9), 1205–1212. [Google Scholar] [CrossRef] [PubMed]
- Hornby, J.M.; Jacobitz-Kizzier, S.M.; McNeel, D.J.; Jensen, E.C.; Treves, D.S.; Nickerson, K.W. Inoculum Size Effect in Dimorphic Fungi: Extracellular Control of Yeast-Mycelium Dimorphism in Ceratocystis ulmi. Appl. Environ. Microbiol. 2004, 70(3), 1356–1359. [Google Scholar] [CrossRef] [PubMed]
- Beauvais, A.; Schmidt, C.; Guadagnini, S.; Roux, P.; Perret, E.; Henry, C.; Paris, S.; Mallet, A.; Prévost, M.-C.; Latgé, J.P. An Extracellular Matrix Glues Together the Aerial-Grown Hyphae of Aspergillus fumigatus. Cell Microbiol. 2007, 9(6), 1588–1600. [Google Scholar] [CrossRef]
- Gamarra, N.N.; Villena, G.K.; Gutiérrez-Correa, M. Cellulase Production by Aspergillus niger in Biofilm, Solid-State, and Submerged Fermentations. Appl. Microbiol. Biotechnol. 2010, 87(2), 545–551. [Google Scholar] [CrossRef]
- Villena, G.K.; Gutierrez-Correa, M. Production of Cellulase by Aspergillus niger Biofilms Developed on Polyester Cloth. Lett. Appl. Microbiol. 2006, 43(3), 262–268. [Google Scholar] [CrossRef]
- Villena, G.K.; Gutiérrez-Correa, M. Morphological Patterns of Aspergillus niger Biofilms and Pellets Related to Lignocellulolytic Enzyme Productivities. Lett. Appl. Microbiol. 2007, 45(3), 231–237. [Google Scholar] [CrossRef]
- Rayón-López, G.; Carapia-Minero, N.; Medina-Canales, M.G.; García-Pérez, B.E.; Reséndiz-Sánchez, J.; Pérez, N.O.; Rodríguez-Tovar, A.V.; Ramírez-Granillo, A. Lipid-Like Biofilm from a Clinical Brain Isolate of Aspergillus terreus: Quantification, Structural Characterization and Stages of the Formation Cycle. Mycopathologia 2023, 188(1–2), 35–49. [Google Scholar] [CrossRef]
- Fiori, B.; Posteraro, B.; Torelli, R.; Tumbarello, M.; Perlin, D.S.; Fadda, G.; Sanguinetti, M. In vitro Activities of Anidulafungin and Other Antifungal Agents against Biofilms Formed by Clinical Isolates of Different Candida and Aspergillus Species. Antimicrob. Agents Chemother. 2011, 55(6), 3031–3035. [Google Scholar] [CrossRef]
- Francis, F.; Druart, F.; Mavungu, J.D.D.; De Boevre, M.; De Saeger, S.; Delvigne, F. Biofilm Mode of Cultivation Leads to an Improvement of the Entomotoxic Patterns of Two Aspergillus Species. Microorganisms 2020, 8(5), 705. [Google Scholar] [CrossRef]
- Wuren, T.; Toyotome, T.; Yamaguchi, M.; Takahashi-Nakaguchi, A.; Muraosa, Y.; Yahiro, M.; Wang, D.-N.; Watanabe, A.; Taguchi, H.; Kamei, K. Effect of Serum Components on Biofilm Formation by Aspergillus fumigatus and Other Aspergillus Species. Jpn. J. Infect. Dis. 2014, 67(3), 172–179. [Google Scholar] [CrossRef] [PubMed]
- Priegnitz, B.-E.; Wargenau, A.; Brandt, U.; Rohde, M.; Dietrich, S.; Kwade, A.; Krull, R.; Fleißner, A. The Role of Initial Spore Adhesion in Pellet and Biofilm Formation in Aspergillus niger. Fungal Genet. Biol. 2012, 49(1), 30–38. [Google Scholar] [CrossRef] [PubMed]
- Gow, N.A.R.; Latge, J.-P.; Munro, C.A. The Fungal Cell Wall: Structure, Biosynthesis, and Function. Microbiol. Spectr. 2017, 5(3), 5.3.01. [Google Scholar] [CrossRef] [PubMed]
- Wu, M.-Y.; Mead, M.E.; Kim, S.-C.; Rokas, A.; Yu, J.-H. WetA Bridges Cellular and Chemical Development in Aspergillus flavus. PLoS ONE 2017, 12(6), e0179571. [Google Scholar] [CrossRef] [PubMed]
- Mowat, E.; Lang, S.; Williams, C.; McCulloch, E.; Jones, B.; Ramage, G. Phase-Dependent Antifungal Activity against Aspergillus fumigatus Developing Multicellular Filamentous Biofilms. J. Antimicrob. Chemother. 2008, 62(6), 1281–1284. [Google Scholar] [CrossRef]
- Cho, H.-J.; Son, S.-H.; Chen, W.; Son, Y.-E.; Lee, I.; Yu, J.-H.; Park, H.-S. Regulation of Conidiogenesis in Aspergillus flavus. Cells 2022, 11(18), 2796. [Google Scholar] [CrossRef]
- Zhang, J.; Chen, H.; Sumarah, M.W.; Gao, Q.; Wang, D.; Zhang, Y. veA Gene Acts as a Positive Regulator of Conidia Production, Ochratoxin A Biosynthesis, and Oxidative Stress Tolerance in Aspergillus niger. J. Agric. Food Chem. 2018, 66(50), 13199–13208. [Google Scholar] [CrossRef]
- Corrêa-Almeida, C.; Borba-Santos, L.P.; Rollin-Pinheiro, R.; Barreto-Bergter, E.; Rozental, S.; Kurtenbach, E. Characterization of Aspergillus nidulans Biofilm Formation and Structure and Their Inhibition by Pea Defensin Psd2. Front. Mol. Biosci. 2022, 9, 795255. [Google Scholar] [CrossRef]
- Chatterjee, S.; Das, S. Developmental Stages of Biofilm and Characterization of Extracellular Matrix of Manglicolous Fungus Aspergillus niger BSC-1. J. Basic. Microbiol. 2020, 60(3), 231–242. [Google Scholar] [CrossRef]
- Mitchell, K.F.; Zarnowski, R.; Andes, D.R. Fungal Super Glue: The Biofilm Matrix and Its Composition, Assembly, and Functions. PLoS Pathog. 2016, 12(9), e1005828. [Google Scholar] [CrossRef]
- Nett, J.E.; Andes, D.R. Contributions of the Biofilm Matrix to Candida Pathogenesis. JoF 2020, 6(1), 21. [Google Scholar] [CrossRef] [PubMed]
- Flemming, H.-C.; Wingender, J. The Biofilm Matrix. Nat. Rev. Microbiol. 2010, 8(9), 623–633. [Google Scholar] [CrossRef] [PubMed]
- Erwig, L.P.; Gow, N.A.R. Interactions of Fungal Pathogens with Phagocytes. Nat. Rev. Microbiol. 2016, 14(3), 163–176. [Google Scholar] [CrossRef] [PubMed]
- Reichhardt, C.; Ferreira, J.A.G.; Joubert, L.-M.; Clemons, K.V.; Stevens, D.A.; Cegelski, L. Analysis of the Aspergillus fumigatus Biofilm Extracellular Matrix by Solid-State Nuclear Magnetic Resonance Spectroscopy. Eukaryot. Cell 2015, 14(11), 1064–1072. [Google Scholar] [CrossRef]
- Zarnowski, R.; Westler, W.M.; Lacmbouh, G.A.; Marita, J.M.; Bothe, J.R.; Bernhardt, J.; Lounes-Hadj Sahraoui, A.; Fontaine, J.; Sanchez, H.; Hatfield, R.D.; Ntambi, J.M.; Nett, J.E.; Mitchell, A.P.; Andes, D.R. Novel Entries in a Fungal Biofilm Matrix Encyclopedia. mBio 2014, 5(4), e01333-14. [Google Scholar] [CrossRef]
- Mosier, A.C.; Li, Z.; Thomas, B.C.; Hettich, R.L.; Pan, C.; Banfield, J.F. Elevated Temperature Alters Proteomic Responses of Individual Organisms within a Biofilm Community. The ISME Journal 2015, 9(1), 180–194. [Google Scholar] [CrossRef]
- Obana, N.; Nakamura, K.; Nomura, N. A Sporulation Factor Is Involved in the Morphological Change of Clostridium perfringens Biofilms in Response to Temperature. J. Bacteriol. 2014, 196(8), 1540–1550. [Google Scholar] [CrossRef]
- Obana, N.; Nakamura, K.; Nomura, N. Temperature-Regulated Heterogeneous Extracellular Matrix Gene Expression Defines Biofilm Morphology in Clostridium perfringens. npj Biofilms Microbiomes 2020, 6(1), 29. [Google Scholar] [CrossRef]
- Casagrande Pierantoni, D.; Corte, L.; Casadevall, A.; Robert, V.; Cardinali, G.; Tascini, C. How Does Temperature Trigger Biofilm Adhesion and Growth in Candida albicans and Two Non- Candida albicans Candida Species? Mycoses 2021, 64(11), 1412–1421. [Google Scholar] [CrossRef]
- Pumeesat, P.; Muangkaew, W.; Ampawong, S.; Luplertlop, N. Candida albicans Biofilm Development under Increased Temperature. New Microbiol 2017, 40(4), 279–283. [Google Scholar]
- Shopova, I.; Bruns, S.; Thywissen, A.; Kniemeyer, O.; Brakhage, A.A.; Hillmann, F. Extrinsic Extracellular DNA Leads to Biofilm Formation and Colocalizes with Matrix Polysaccharides in the Human Pathogenic Fungus Aspergillus fumigatus. Front. Microbiol. 2013, 4. [Google Scholar] [CrossRef] [PubMed]
- Rajendran, R.; Williams, C.; Lappin, D.F.; Millington, O.; Martins, M.; Ramage, G. Extracellular DNA Release Acts as an Antifungal Resistance Mechanism in Mature Aspergillus fumigatus Biofilms. Eukaryot. Cell 2013, 12(3), 420–429. [Google Scholar] [CrossRef] [PubMed]
- Martins, M.; Henriques, M.; Lopez-Ribot, J.L.; Oliveira, R. Addition of DNase Improves the in vitro Activity of Antifungal Drugs against Candida albicans Biofilms. Mycoses 2012, 55(1), 80–85. [Google Scholar] [CrossRef] [PubMed]
- Emri, T.; Molnár, Z.; Szilágyi, M.; Pócsi, I. Regulation of Autolysis in Aspergillus nidulans. Appl. Biochem. Biotechnol. 2008, 151(2–3), 211–220. [Google Scholar] [CrossRef] [PubMed]
- Karygianni, L.; Ren, Z.; Koo, H.; Thurnheer, T. Biofilm Matrixome: Extracellular Components in Structured Microbial Communities. Trends Microbiol. 2020, 28(8), 668–681. [Google Scholar] [CrossRef]
- Thi, M.T.T.; Wibowo, D.; Rehm, B.H.A. Pseudomonas aeruginosa Biofilms. IJMS 2020, 21(22), 8671. [Google Scholar] [CrossRef]
- Reichhardt, C.; Stevens, D.A.; Cegelski, L. Fungal Biofilm Composition and Opportunities in Drug Discovery. Future Med. Chem. 2016, 8(12), 1455–1468. [Google Scholar] [CrossRef]
- Němcová, A.; Szotkowski, M.; Samek, O.; Cagáňová, L.; Sipiczki, M.; Márová, I. Use of Waste Substrates for the Lipid Production by Yeasts of the Genus Metschnikowia—Screening Study. Microorganisms 2021, 9(11), 2295. [Google Scholar] [CrossRef]
- Andrews, J.S.; Rolfe, S.A.; Huang, W.E.; Scholes, J.D.; Banwart, S.A. Biofilm Formation in Environmental Bacteria Is Influenced by Different Macromolecules Depending on Genus and Species. Environ. Microbiol. 2010, 12(9), 2496–2507. [Google Scholar] [CrossRef]
- Kuroiwa, T.; Ohnuma, M.; Imoto, Y.; Misumi, O.; Fujiwara, T.; Miyagishima, S.; Sumiya, N.; Kuroiwa, H. Lipid Droplets of Bacteria, Algae and Fungi and a Relationship between Their Contents and Genome Sizes as Revealed by BODIPY and DAPI Staining. cytologia 2012, 77(3), 289–299. [Google Scholar] [CrossRef]
- Graef, M. Lipid Droplet-mediated Lipid and Protein Homeostasis in Budding Yeast. FEBS Letters 2018, 592(8), 1291–1303. [Google Scholar] [CrossRef] [PubMed]
- Hapala, I.; Griac, P.; Holic, R. Metabolism of Storage Lipids and the Role of Lipid Droplets in the Yeast Schizosaccharomyces pombe. Lipids 2020, 55(5), 513–535. [Google Scholar] [CrossRef] [PubMed]
- Péter, M.; Glatz, A.; Gudmann, P.; Gombos, I.; Török, Z.; Horváth, I.; Vígh, L.; Balogh, G. Metabolic Crosstalk between Membrane and Storage Lipids Facilitates Heat Stress Management in Schizosaccharomyces pombe. PLoS ONE 2017, 12(3), e0173739. [Google Scholar] [CrossRef] [PubMed]
- Schepers, J.; Behl, C. Lipid Droplets and Autophagy—Links and Regulations from Yeast to Humans. J. of Cellular Biochemistry 2021, 122(6), 602–611. [Google Scholar] [CrossRef] [PubMed]
- Hanano, A.; Alkara, M.; Almousally, I.; Shaban, M.; Rahman, F.; Hassan, M.; Murphy, D.J. The Peroxygenase Activity of the Aspergillus flavus Caleosin, AfPXG, Modulates the Biosynthesis of Aflatoxins and Their Trafficking and Extracellular Secretion via Lipid Droplets. Front. Microbiol. 2018, 9, 158. [Google Scholar] [CrossRef]
- Kobae, Y.; Gutjahr, C.; Paszkowski, U.; Kojima, T.; Fujiwara, T.; Hata, S. Lipid Droplets of Arbuscular Mycorrhizal Fungi Emerge in Concert with Arbuscule Collapse. Plant Cell Physiol. 2014, 55(11), 1945–1953. [Google Scholar] [CrossRef]
- Qin, P.; Wang, Z.; Lu, D.; Kang, H.; Li, G.; Guo, R.; Zhao, Y.; Han, R.; Ji, B.; Zeng, Y. Neutral Lipid Content in Lipid Droplets: Potential Biomarker of Cordycepin Accumulation in Cordycepin-Producing Fungi. Molecules 2019, 24(18), 3363. [Google Scholar] [CrossRef]
- Lattif, A.A.; Mukherjee, P.K.; Chandra, J.; Roth, M.R.; Welti, R.; Rouabhia, M.; Ghannoum, M.A. Lipidomics of Candida albicans Biofilms Reveals Phase-Dependent Production of Phospholipid Molecular Classes and Role for Lipid Rafts in Biofilm Formation. Microbiology 2011, 157(11), 3232–3242. [Google Scholar] [CrossRef]
- Srinivasan, N.; Thangavelu, K.; Uthandi, S. Lovastatin Production by an Oleaginous Fungus, Aspergillus terreus KPR12 Using Sago Processing Wastewater (SWW). Microb. Cell Fact. 2022, 21(1), 22. [Google Scholar] [CrossRef]
- Kamoun, O.; Ayadi, I.; Guerfali, M.; Belghith, H.; Gargouri, A.; Trigui-Lahiani, H. Fusarium verticillioides as a Single-Cell Oil Source for Biodiesel Production and Dietary Supplements. PSEP 2018, 118, 68–78. [Google Scholar] [CrossRef]
- Papanikolaou, S.; Dimou, A.; Fakas, S.; Diamantopoulou, P.; Philippoussis, A.; Galiotou-Panayotou, M.; Aggelis, G. Biotechnological Conversion of Waste Cooking Olive Oil into Lipid-Rich Biomass Using Aspergillus and Penicillium Strains: Waste Oil Valourization by Higher Fungi. J. App Microbiol. 2011, 110(5), 1138–1150. [Google Scholar] [CrossRef] [PubMed]
- Nett, J.E.; Sanchez, H.; Cain, M.T.; Andes, D.R. Genetic Basis of Candida Biofilm Resistance Due to Drug-Sequestering Matrix Glucan. J. INFECT DIS 2010, 202(1), 171–175. [Google Scholar] [CrossRef] [PubMed]
- Suzuki, H.; Taketani, T.; Kobayashi, J.; Ohshiro, T. Antibiotic Resistance Mutations Induced in Growing Cells of Bacillus-Related Thermophiles. J. Antibiot. 2018, 71(3), 382–389. [Google Scholar] [CrossRef] [PubMed]
- Huang, J.; Hu, P.; Ye, L.; Shen, Z.; Chen, X.; Liu, F.; Xie, Y.; Yu, J.; Fan, X.; Xiao, M.; Tsui, C.K.M.; Wang, W.; Li, Y.; Zhang, G.; Wong, K.H.; Cai, L.; Bai, F.; Xu, Y.; Wang, L. Pan-Drug Resistance and Hypervirulence in a Human Fungal Pathogen Are Enabled by Mutagenesis Induced by Mammalian Body Temperature. Nat. Microbiol. 2024, 9(7), 1686–1699. [Google Scholar] [CrossRef]
- Chandra, J.; Kuhn, D.M.; Mukherjee, P.K.; Hoyer, L.L.; McCormick, T.; Ghannoum, M.A. Biofilm Formation by the Fungal Pathogen Candida albicans: Development, Architecture, and Drug Resistance. J. Bacteriol. 2001, 183(18), 5385–5394. [Google Scholar] [CrossRef]
- Fattahi, M.; Ghasemi, R.; Pinegina, O.; Bahrami, M.M.; Hosseini, M.; Lotfali, E. Effect of Voriconazole on Biofilm of Filamentous Species Isolated from Keratitis. Arch. Clin. Infect. Dis. 2022, 16(6). [Google Scholar] [CrossRef]
- Turan, H.; Demirbilek, M. Biofilm-Forming Capacity of Blood–Borne Candida albicans Strains and Effects of Antifungal Agents. Rev. Argent. Microbiol. 2018, 50(1), 62–69. [Google Scholar] [CrossRef]
- LaFleur, M.D.; Kumamoto, C.A.; Lewis, K. Candida albicans Biofilms Produce Antifungal-Tolerant Persister Cells. Antimicrob. Agents Chemother. 2006, 50(11), 3839–3846. [Google Scholar] [CrossRef]

| Amphotericin B (µg/mL) |
Itraconazole (µg/mL) |
|||
|---|---|---|---|---|
| PK | BF | PK | BF | |
| 28 °C | 1 | >16 | 0.0625 | >16 |
| 37 °C | 2 | >16 | 0.25 | >16 |
| 42 °C | 1 | >16 | 0.0625 | >16 |
Disclaimer/Publisher’s Note: The statements, opinions and data contained in all publications are solely those of the individual author(s) and contributor(s) and not of MDPI and/or the editor(s). MDPI and/or the editor(s) disclaim responsibility for any injury to people or property resulting from any ideas, methods, instructions or products referred to in the content. |
© 2024 by the authors. Licensee MDPI, Basel, Switzerland. This article is an open access article distributed under the terms and conditions of the Creative Commons Attribution (CC BY) license (https://creativecommons.org/licenses/by/4.0/).
